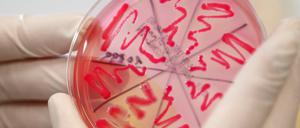
Schwere Darmerkrankungen mit dem gefährlichen EHEC-Erreger breiten sich in Deutschland weiter aus.

Kiel wehrt sich gegen Kritik des Wissenschaftsrats
Schleswig-Holstein

Eine Lücke ist geschlossen: Nun gehört das gesamte deutsche Wattenmeer zum Welterbe. Wie auch prähistorische Pfahlbauten in Baden-Württemberg und Bayern erhielt der Nationalpark Hamburgisches Wattenmeer den prestigeträchtigen Titel.

Der Atomausstieg erreicht die Bilanzen der Atomkonzerne. Vattenfall verzeichnet Belastungen in Milliardenhöhe. RWE klagt nun gemeinsam mit Eon gegen die Atomsteuer.

Sprossen sind eindeutig als Träger des gefährlichen Ehec-Bakteriums ausgemacht. Bundesweit ebbt die Ehec-Welle angeblich ab. Nun fällt erstmals ein Kind der gefährlichen Darmerkrankung zum Opfer.
Eine Fülle von Genen steuert Ausmaß und Verlauf der Mukoviszidose. Vorbeugende Maßnahmen sind derzeit in der Erprobung.
Die deutschen Behörden warnen weiter vor dem Verzehr von rohen Tomaten, Salatgurken und Blattsalaten. Diese vorsorglichen Hinweise gelten besonders für in Norddeutschland erhältliche Ware und würden von zwei neuen Studien bestätigt, wie das Robert-Koch-Institut (RKI) mitteilte.
Die Herkunft des Ehec-Erreger ist noch nicht gefunden. Und es gibt immer neue Krankheitsfälle. Der Druck auf Behörden und medizinische Institutionen wächst. Wie ernst ist die Lage?

In Norddeutschland stoßen die Kliniken wegen des EHEC-Erregers an ihre Grenzen. Patienten drohen neurologische Folgeschäden. Hamburgs Bürgermeister Olaf Scholz ruft zu Blutspenden auf.
In Nordrhein-Westfalen ist eine 91-jährige Frau an den Folgen einer EHEC-Infektion gestorben. Die Zahl der Neuerkrankungen sei indessen rückläufig, heißt es aus Hamburg.
Auf einmal steht Berlin in Deutschland wieder so ähnlich da wie Griechenland in Europa, als verschwenderischer, fauler und ein bisschen auch asozialer Nachbar, der zwar gerettet wird, zähneknirschend, aber nur um den Preis seiner Haushaltskapitulation.

Mehr Tote, weitere Kranke: In Lübeck stirbt eine ältere Frau. Ihr Ehemann liegt mit der gefährlichen Darminfektion im selben Krankenhaus. Die Deutschen verzichten derzeit mehrheitlich auf rohe Tomaten, Gurken und Salat.
Der Maler Jens Lorenzen schafft ein eigenes Universum aus Medienbildern / Zu sehen im Kunstkontor

Potsdam - Auch der Auftritt von Wirtschaftsminister Ralf Christoffers (Linke) half nichts mehr. Das Bundesland Brandenburg blieb bei seinen Versuchen im Bundesrat, eine ihm genehme Regelung im CCS-Gesetz zur CO2-Speicherung durchzusetzen, weitgehend allein.
Patientin war zuvor in Schleswig-Holstein. Noch keine Laborergebnisse zu Potsdamer Verdachtsfall
Es kann lebensbedrohlich sein. Das Darmbakterium EHEC breitet sich in Norddeutschland rasant aus. Wie ernst ist die Lage?
Die Welle von schweren Darminfektionen in Norddeutschland hat nun Todesopfer gefordert. Eine 83-jährige Frau im niedersächsischen Landkreis Diepholz ist der Krankheit erlegen. Bei einem weiteren Todesfall ist noch unklar, ob eine EHEC-Infektion Ursache war.

Update. Nach dem EHEC-Ausbruch arbeiten die Forscher unter Hochdruck. Das Robert-Koch-Institut warnt inzwischen davor, rohe Tomaten, Salatgurken und Blattsalate aus Norddeutschland zu essen.

Ein bisschen Amerika weht durch die SPD. Die Parteispitze will ihren Kanzlerkandidaten durch alle Bürger wählen lassen. Viele Landesverbände haben für die Idee nur eines übrig: Ablehnung.

Warum sparen, wenn mich der reiche Nachbar alimentiert? Berlin droht die Finanzaufsicht. Das ist gut, schreibt Malte Lehming im "Kontrapunkt". Noch besser wäre es, das Stadtstaatenprivileg würde zur Disposition gestellt.
Stabilitätsrat sieht drohende Haushaltsnotlage
Unter stärkerer Finanzaufsicht: Wegen drohender Haushaltsnotlage werden Berlin, Bremen, das Saarland sowie Schleswig-Holstein schärfer an die Kandare genommen.

Vier Bundesländer stehen vor einer Haushaltsnotlage – nun muss saniert werden. Berlins Finanzsenator Nußbaum sieht Berlin bereit für ein hartes Sanierungsprogramm.

Immer mehr Menschen erkranken am EHEC-Erreger, einer schweren Durchfallerkrankung. Nach wie vor suchen die Behörden nach dem Auslöser für die Infektionen.
Berlin - Mutmaßlich rechtsextreme Täter haben im vergangenen Jahr 41-mal jüdische Friedhöfe attackiert. Am stärksten betroffen war Nordrhein-Westfalen, hier wurden elf Schändungen verübt.
Noch bevor die Reaktorsicherheitskommission (RSK) am Dienstag ihren Bericht über die Sicherheit deutscher Atomkraftwerke übergeben hat, gibt es bereits Kritik. Die Atomaufsicht in Schleswig-Holstein moniert in einem Brief an die RSK, „dass in dem engen zeitlichen Rahmen viele Fragen von den Betreibern nicht mit der für eine atomaufsichtliche Bewertung erforderlichen Qualität beantwortet werden konnten“.
Mutmaßlich rechtsextreme Täter haben im vergangenen Jahr nach Informationen des Tagesspiegels bundesweit 41 Mal jüdische Friedhöfe attackiert. Nur vier Fälle wurden aufgeklärt.
2016 gilt als realistischer Termin. Die Steuereinnahmen steigen in den nächsten Jahren kräftig

Der Bund als Retter der Spitzenforschung: Für die Charité könnte das schon bald Wirklichkeit werden. Schavans Pläne sind weit gediehen.
Das in die Kritik geratene Marine-Segelschulschiff "Gorch Fock" hat die Kieler Bucht erreicht. Am Freitag soll es in Kiel festmachen. Doch schon heute Abend bekommt die Mannschaft Besuch.
Berlin - Die Debatte um einen Neuanfang in der FDP verschärft sich. Der stellvertretende Vorsitzende der FDP-Bundestagsfraktion, Jürgen Koppelin, stellt in einem Positionspapier den kompletten Fraktionsvorstand der liberalen Bundestagsfraktion zur Disposition und fordert die Partei auf, „unsere Ziele zu überdenken und Korrekturen vorzunehmen“.

Die Debatte um einen personellen und inhaltlichen Neuanfang in der FDP verschärft sich wieder. Fraktionsvize Jürgen Koppelin fordert eine Vertrauensfrage und er greift Fraktionschefin Birgit Homburger frontal an.
Potsdam - Brandenburgs Ministerpräsident Matthias Platzeck (SPD) hat das politische und menschliche Vermächtnis der früheren Sozialministerin Regine Hildebrandt gewürdigt. Diese habe sich stets für die Schwachen in der Gesellschaft eingesetzt, sagte Platzeck am Dienstag zum 70.
W er auf dem Tiger reiten möchte, muss aufpassen, dass er nicht herunterfällt – sonst wird er gefressen. Diese Klugheitsregel gilt auch in der Politik, vor allem dann, wenn man glaubt, man solle mit dem Volkswillen seine Spielchen treiben.
W er auf dem Tiger reiten möchte, muss aufpassen, dass er nicht herunterfällt – sonst wird er gefressen. Diese Klugheitsregel gilt auch in der Politik, vor allem dann, wenn man glaubt, man solle mit dem Volkswillen seine Spielchen treiben.

Grünen-Fraktionschef Jürgen Trittin spricht im Interview mit dem Tagesspiegel über Tempo und Kosten des Atomausstiegs sowie den Höhenflug seiner Partei.
„Ackerstaub nahm den Fahrern die Sicht“ vom 9. April Es mag sein, dass es aus meteorologischer Sicht kein Mittel gegen solche Sandstürme, wie sie auf der A 19 geschahen, gibt.

Berlin und vier andere Länder haben sich verpflichtet: Die Neuverschuldung muss runter. Berlin verzichtet für Bundeshilfen auf einen Teil seiner Autonomie.
Merkel: Haben Brandenburg mit dem Gesetz eine Freude gemacht. Christoffers befürchtet Erklärungsnot
Merkel: Haben Brandenburg mit dem Gesetz eine Freude gemacht. Christoffers befürchtet Erklärungsnot

Im Landtag spricht sich nur die CDU für die CCS-Technologie und Kohlendioxid-Endlager aus